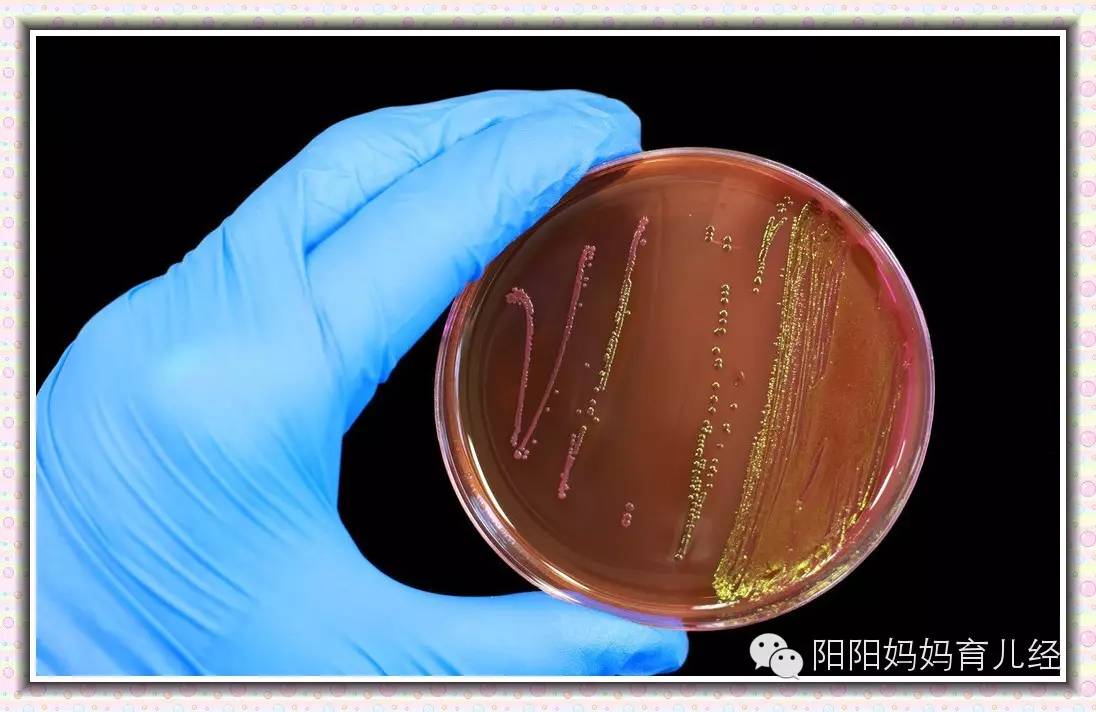
养孩子每天消毒,养孩子是干净点好还是脏点好

先自我介绍一下,阳妈是一名致力于微生物感染工作10余年的临床医生,也是一位热衷于育儿的宝妈。所以,今天的话题,阳妈将结合自己的工作和育儿经验与大家共同分享。
绝大多数父母的微生物观念
当拥有宝宝的以后,父母都会非常精心地去呵护这个小生命,免受疾病的困扰,其中,很大程度上,希望孩子免受各种微生物的感染。的确,根据小儿生理特点,他们上呼吸道、消化道与成人相比,更容易被侵袭。于是,各种微生物一致称为众矢之的,成为各位爸妈的防御对象。每吃一次奶的奶瓶,消毒;宝宝的玩具必须用酒精擦拭后才觉得安全;孩子的衣物都用消毒剂混合洗衣液彻底清洗。总而言之,妈妈们想尽一切招数,把自己对于“微生物”的认识发挥到了极致,而这么做的目的只有一个,让宝宝逃离细菌,不受感染侵害。
这种观念真的对吗?
从一个资深感染性疾病医生的角度,阳妈说:以上观念和言论,都是非常狭隘的。
今天我要从专业的角度,给大家树立科学的“婴幼儿微生物生存观”。
微生物包括细菌、病毒、支原体、衣原体等多种,阳妈今天主要和大家讲和宝宝成长最密切的“细菌”。

“身体”是人和微生物共同生存的家
身体健康状况在很大程度上依赖于人体与微生物相互竞争、生存平衡的状态。所有身体对外开放的管道和腔隙都是由细菌把守,比如消化道,上呼吸道,阴道。
这些可爱的小生物并非只有一种,而是由多种细菌组成组成,并在身体局部形成群落,他们维持自己生存的同时,与人类保持竞争平衡、相互促进的关系。正常情况下,他们能有效的抑制外来的有害微生物的侵袭,并且能够最大程度降低局部定植条件致病菌对人体潜在威胁。也就是说,细菌也分好坏,人体的正常菌群是人类好的伙伴,真正对人类致病的坏细菌是外来者或局部定植的条件致病菌。当各种原因引起的局部正常菌群紊乱或人体免疫低下时,坏细菌才会引发感染。条件致病菌是正常菌群的一部分,平常与菌群里的其他细菌保持平衡,其只有满足一定条件,才会对人体致病。
人类口腔和上呼吸道的正常菌群主要有各种链球菌,葡萄球菌,奈瑟氏菌等。在人类消化道,主要是大肠杆菌和肠球菌,其中以大肠杆菌占绝对多数。
当宝宝吃了含有外来致病性细菌的食物时,肠道的正常菌群能够帮助宝宝起到很好的防护和缓冲。可是,如果这个宝宝肠道菌群结构不完善或当有害细菌的危害能力超过胃肠道菌群的缓冲作用时,宝宝才会出现腹泻、便秘、呕吐等一系列消化道和全身症状。这就是为什么同样吃同一种食物,有的孩子会腹泻,而有的宝宝不会,因为他们胃肠道菌群的缓冲能力以及机体的免疫水平各有差异。此刻,细心的妈妈就会明白,为何医生在宝宝胃肠道出现问题时,会给孩子开益生菌来进行治疗了。
我们作为父母,应该做的是帮助宝宝建立起自己正常的菌群结构,而不是一味的杀灭细菌,因为,事实是:如果好细菌被杀死了,孩子的健康才会真正面临威胁。

出生后与细菌的第一次重要亲密接触
宝宝在妈妈宫腔里是绝对无菌的,因为宫腔里纯净的环境才能保证胎儿健康成长,避免各种发育畸形和感染的产生。但是,自从来到世界的这一刻开始,孩子就本能地试图开始通过各种方式与微生物共存。
第一次接触微生物的方式是经阴道正常分娩。女性阴道里和肛门附近的细菌成为宝宝首先接触到的有益细菌。这样的描述看起来有些可笑,大家会非常疑惑:阴道里和肛门附近的细菌那么“肮脏”,怎么可能对于宝宝是有益细菌呢?正常妈妈阴道里的细菌是以乳杆菌为主,而肛门附近的细菌来自于肠道,肠道里的细菌以大肠杆菌为主。当宝宝通过口腔、皮肤与这些细菌亲密接触以后,对于宝宝建立皮肤表面和肠道里的正常菌群非常有利。
这个结论可以在宝宝后期的生长过程中的到体现:由于肠道菌群不健全,孩子出生早期的大便都偏稀,但是随着宝宝肠道菌群的完善,逐渐就会形成更加有规律和质感的大便。事实上,正常人体大便的主要成分是大肠杆菌,其次才是食物残渣,正是肠道里的这些有益细菌才能保证孩子正常的生长、发育、营养吸收及免疫系统成熟。如果没有肠道正常菌群,那么人真的很难存活,此处这么说貌似危言耸听,实际上就是真的如此。
很多年前,医学上就有使用正常人大便挽救因肠道菌群严重失调的危重病人的先例。肠道内细菌结构改变和完善伴随着孩子的整个成长过程,只有菌群完善了,孩子的消化、吸收、免疫等各方面才能保持健康和平衡。
对于剖宫产方式诞生的孩子,其肠道正常菌群建立的时间会晚于经阴道分娩的宝宝,所以这些孩子会面临相对更加多的肠道风险和感染的机会。而科学研究显示,如果能通过人为途径,比如用使用接触到妈妈外阴和阴道细菌的布去擦拭剖宫产宝宝身体和口腔,那么这些宝宝将会获得与阴道分娩相似的肠道菌群结构。
经阴道分娩的宝宝之所以能够在一出生就更胜一筹,很大程度上有赖于母亲传递给宝宝的这些珍贵的细菌。

来自母乳的细菌为孩子成长保驾护航
母乳喂养是孩子第二次接触到珍贵细菌的机会。母乳并非完全无菌,在乳管里和乳头附近的皮肤上,都会存在对宝宝肠道和上呼吸道非常有益的细菌。而且,母乳里含有丰富的益生元(比如低聚半乳糖,即GOS),帮助母乳喂养的宝宝建立良好的肠道菌群。
母乳喂养的宝宝肠道正常菌群以双歧杆菌为主,其让肠道保持偏酸性的环境,有益于机体更好的抵御外来感染。所以,细心的妈妈会发现,这些宝宝的便便会呈现出酸酸的味道。而牛奶喂养的宝宝肠道菌群是以大肠杆菌为主,所以他们的便便无论从形态到味道都更接近于成年人。和母乳喂养的宝宝相比,牛奶喂养的孩子没有双歧杆菌的保护,虽然肠道以大肠杆菌为主,但是肠道的免疫功能还不完善,所以这些孩子就更易于遭受消化道感染。
随着宝宝辅食的添加和奶量的调整,孩子会接触到越来越多的细菌种类,丰富肠道正常菌群,从而让宝宝肠道功能更加完善。所以,孩子肠道的成长不仅仅是结构的长大和完善,更重要的体现在肠道菌群的完善。

孩子呼吸道感染,细菌不负主要责任。
上呼吸道也存在着重要的菌群生态系统。科学显示,对于感染和非感染的宝宝,他们的上呼吸道表现出不同的菌群结构,而且随着宝宝感染性疾病的恢复,上呼吸道异常的菌群也会逐渐趋于正常。绝大多数情况下,引起孩子呼吸道感染的微生物都是病毒而并非细菌。只有在病毒感染的后期,如果由于机体局部免疫力异常和菌群紊乱,才有可能让条件致病菌肆意繁殖,从而形成“细菌和病毒”联合感染人体的状态。
但是,的确也有一些细菌更倾向于侵袭免疫屏障不完善的小儿,比如肺炎链球菌,流感嗜血杆菌,卡他莫拉氏菌等,所以,各个国家,针对于这些细菌都有相应的疫苗给孩子应用。可喜的是,这些细菌往往对普通的抗生素敏感性都比较好。虽然,近年来,随着抗生素的广泛使用,常常有对某些抗生素的耐药菌株的出现,但是,他们对绝大多数抗生素都是敏感的,也就是说,由于这些细菌引起的疾病都是比较容易控制的。而且随着研究的深入,通过人为引入上呼吸道正常细菌,通过改善正常菌群结构的方式改变机体感染状态,也是大家关注的热点。
同样,事实上在宝宝的上呼吸道,病毒的到来也是常见的情况,但是,如果宝宝身体免疫状况和菌群结构正常,孩子很可能不会表现出明显症状或症状轻微。而且,随着孩子接触到更多种类的微生物后,才能让宝宝身体逐渐建立起针对这些微生物的特异性免疫。接种疫苗就是以这个理论为基础,人为的用减毒或者灭活的微生物的成分去刺激人体,逐渐让人体建立起针对这些微生物的主动免疫。
只有和微生物达成平衡状态,宝宝才能在在自然环境下生存,而这种生存是建立在人体免疫系统和微生物彼此认识和竞争的基础上的。
过敏和感染,此消彼长。
湿疹,过敏性腹泻等过敏现象变得越来越常见,实际上,的确是越来越多的孩子正在经历过敏性疾病的侵袭。事实是,这种现象是随着社会现代化程度提高而明显增多的,而且调查显示:感染性疾病在逐渐减少,伴随的是过敏性疾病的增加。白领等受过更高教育水平的家庭养育的孩子,过敏性疾病的发病率更高;相对于农村孩子而言,城市孩子发生了更多的过敏性疾病;剖宫产、非母乳喂养、抗生素的过早使用、消毒剂的使用都与过敏性疾病正相关。而大家仔细分析这些加速、加重过敏性疾病的因素时都发现,其实过敏和感染是此消彼长的关系,细菌没了,机体的免疫系统就可能面临紊乱,从而导致一系列可能影响孩子一生的疾病。
研究显示,婴儿时期湿疹和更大年龄孩子的哮喘事件成正相关。在幼年时期表现为消化道和皮肤的过敏,长大后就很可能会表现为呼吸系统的过敏(过敏性鼻炎、过敏性哮喘),这被称为过敏进程,即过敏从一个系统表现逐渐转到其他系统的表现。目前较多的科学家支持的观点是:一旦过敏过程被触发,就不会终止,医生能做的只是帮助孩子缓解症状。由此可见,细菌对人体到底有多么重要,而农村孩子散养的孩子有少过敏情况发生的原因,主要是这些孩子得到了更多微生物的保护。
城市、高知父母、过渡干净的环境事实上让宝宝回避微生物的同时,却面临更为复杂的免疫系统的疾病。
通过以上阳妈的描述,大家肯定都会恍然大悟,其实我们和微生物是共存的,没有他们,我们人类无法存活。人和微生物和平相处才是我们真正的和谐健康状态。

关于不消毒宝宝用品而导致腹泻的腹黑言论
绝大多数感染性腹泻,都是由病毒或细菌引起的,而这些有毒力的细菌或病毒,往往都不是我们家庭日常生活中存在的,基本都是通过外来异常摄入而导致的宝宝腹泻。比如吃了没有洗净的蔬菜或水果,或者接触到具有胃肠传染病的病人。导致人体消化道感染的常见细菌有各种有毒力的大肠杆菌(没有毒力的大肠杆菌一般情况下,是不会感染导致宝宝肠道感染的。)、沙门菌、志贺氏菌、弧菌、弯曲菌等,而这些细菌往往都是先污染了食物,然后人体又摄取了没有加工熟的食物,这样人体才被感染的。这些细菌在我们日常生活的家庭小环境里,一般不会存在。
所以,我们防止孩子感染的重点在于让孩子吃烹调熟的食物,不吃陈旧的腐食,不与消化道传染病人接触。

关于幽门螺旋杆菌的问题
很多妈妈会担心,家里有人携带幽门螺旋杆菌会导致孩子罹患疾病。事实上,我们中国人幽门螺旋杆菌的携带率非常高,大约70%人都携带该细菌。可是,杀灭这种细菌并非是针对这些细菌感染的唯一措施,只有那些具有明显严重症状或相关严重疾病(比如胃溃疡、胃癌)的患者,才建议杀灭。而对于其他的无症状者携带者,可以不需要治疗。原因是,一方面这些细菌未必是带有毒力的真正致病菌,另一方面是,面对着如此高的人群携带率,你不知道这次杀灭了,下次某时可能又会被感染。而且,针对儿童的幽门螺旋杆菌,治疗指南也明确指出,针对有比较严重临床症状的孩子,才倾向于杀菌治疗。根据以上阳妈的叙述,其实幽门螺旋杆菌并没有那么可怕。

妈妈怎么做孩子才健康?
在此,阳妈建议以下几点。
1、 尽量保证阴道分娩和母乳喂养。
2、 宝宝用品不要常消毒,拒绝使用各种消毒剂。
父母眼中的“消毒”,其实主要涉及两个方面。第一是通过高温蒸汽或者水煮的方式。另一种是使用消毒剂。
市售的消毒剂绝大多数都是靠“氧化”过程杀灭细菌。可是,事实是,在杀灭细菌的同时,也会损伤孩子自己的皮肤和粘膜。由于消毒剂引发的宝宝肠道损伤屡见不鲜。
通过煮或者蒸的方式消毒,也不需要那么频繁,一周1~2次足矣。因为宝宝家庭日常生活中所面临的细菌基本都不是真正导致孩子感染的细菌,“成功地与环境中微生物共存”是宝宝必备的生存能力。过渡加热消毒只会让塑料等材质加快老化和毒物的释放。这就像我们家庭使用的碗筷一样,估计也没有人把自己天天使用的餐具消毒吧,可是这个人也没有腹泻呀。随着宝宝长大,他的肠道会越来越接近家庭成员,原因就是他们都生活在相同的有细菌的环境下。
3、 宝宝用品消毒的最好方式是彻底清洁
用干净的水清洁吸奶器、奶瓶、餐具就足够了,但要注意,清洁一定要彻底,因为甜美的奶液和食物残渣是细菌最好的培养基。细菌在吸奶器或奶瓶不容易清洗的区域形成大量菌胎(比如吸奶器各个部件相连接的螺丝区域,各种管道的深处,都是不易清洗的盲区。)会影响宝宝健康。所以,针对宝宝用品的每一个部位,选择合适的刷子清洗非常重要。每次清洗时,卸开吸奶器或奶瓶的每一个部件,尤其是各种管路,用刷子深入内部,清洗角落,保证每次彻底清洁干净。清洗过程中可以使用宝宝专用的清洗剂,但一定要保证每次把清洗剂完全冲洗干净,残留的清洗剂对宝宝健康是有危害的。
4、 清洗或消毒完的宝宝用品该如何放置
如果是频繁使用的吸奶器或奶瓶,那么每次清洗干净后,将每一部分组建分开凉干,然后组装(组装前请洗净双手),等待下次使用。如果不常用,那么洗净,凉干,组装好,收藏,待下次使用前再进行清洗、消毒。“干燥”是保证宝宝用品不受污染的最健康方式。
5、 尽量让孩子置身自然环境之中
在家或在户外,不需要让孩子过渡回避灰尘、泥土、植物、小动物等自然的东西。小宝宝外出时,可能会在地上玩泥土,喜欢摸爬滚打或则随便抓玩树叶,喜欢和小动物亲密接触等,这些情况,妈妈们只要保证宝宝不受伤的情况下,不要制止孩子。因为这样养育的孩子才健康。真正导致孩子获得传染性疾病的场所往往是那些室内游了场所(比如海洋球、室内游乐场等),这些区域的玩具常常由于游客众多而无法得到正常清洗,从而导致孩子通过这些玩具表面接触相互传染各种感染性微生物。所以,在这些场所游玩,对于宝宝健康是有挑战的。
6、 不要过渡要求照看孩子的老人“讲卫生”
很多妈妈由于自己追求“干净”的心理原因,过渡要求看护孩子的老人所谓的“无菌操作”,从而引发重重家庭矛盾。事实上,绝大多数妈妈们的这些要求的产生,都是基于对人体没有充分认识的情况下对老人提出的不恰当的要求,实在是伤了感情还没有必要。由此引发的矛盾很可能不利于家庭关系的和谐,也不利于孩子心理的发育。阳妈在此真心建议各位妈妈,及时调整、改变。

孩子是全家的希望,全家每一个成员都希望宝宝健康、快乐的成长。在这样的大前提下,每一位成员都不应该质疑其他人对孩子的“爱”。所以,在这样“爱”的氛围中,请包容和谅解每个人的行为和思想,用科学、乐观的观点协调家人关系、促进孩子身心健康。在这个过程中,妈妈实际上起了举足轻重的作用,让大家学习如何成为真正的好妈妈也是阳妈一直努力传达给大家的信息。
人无完人,妈妈不是天使,也没有哪个专家是绝对权威,自己的孩子是独一无二的,育儿观念没有可复制性,我们每个人都需要在孩子成长*共中**同经历,共同学习,然后因“孩”制宜。
以上是阳妈今天想分享的内容,希望阳妈今天的分享能帮助大家科学、健康的养育我们的孩子。
阳妈的网络文章会首先在:
微信公众号:阳阳妈妈育儿经 发表
如果想第一时间获得阳妈以后持续推送的育儿知识,请关注阳妈微信公众号“阳阳妈妈育儿经”(用微信搜索 “阳阳妈妈育儿经” 或YYMMYEJ,选择关注即可。).